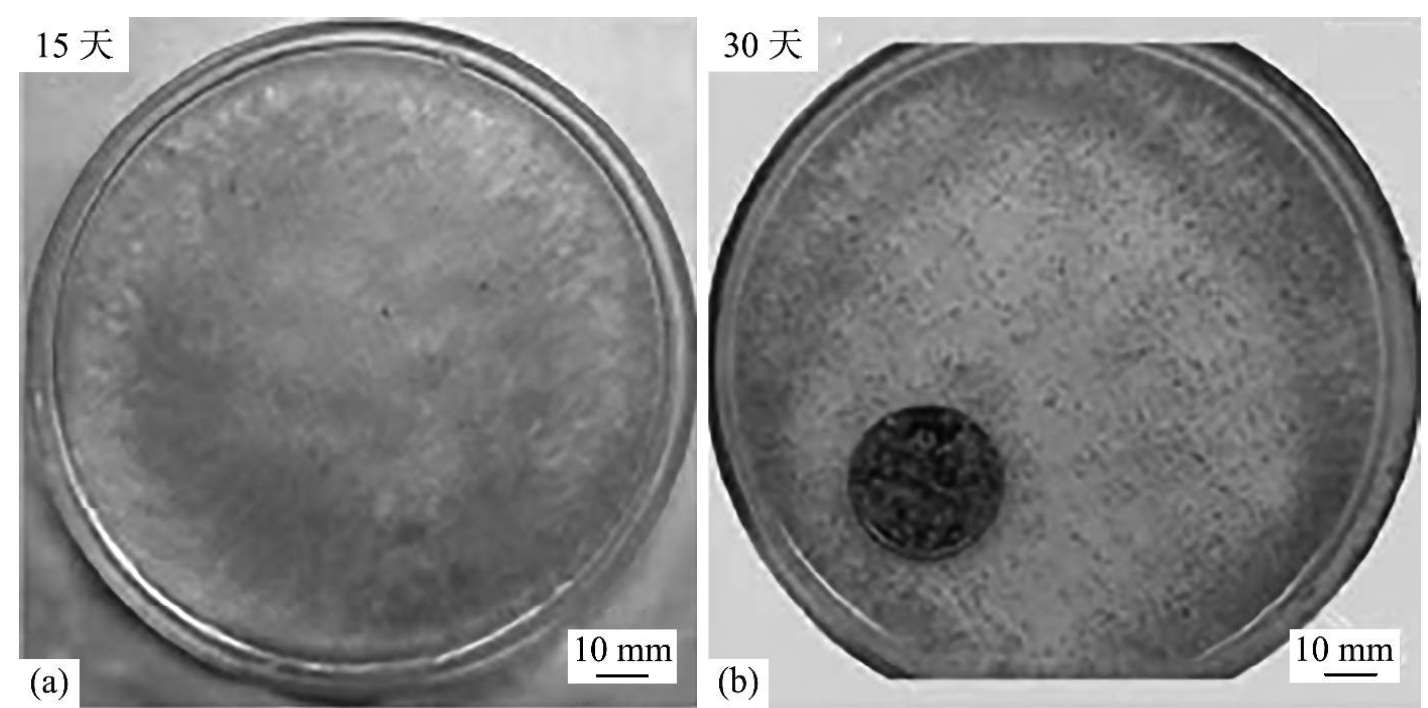
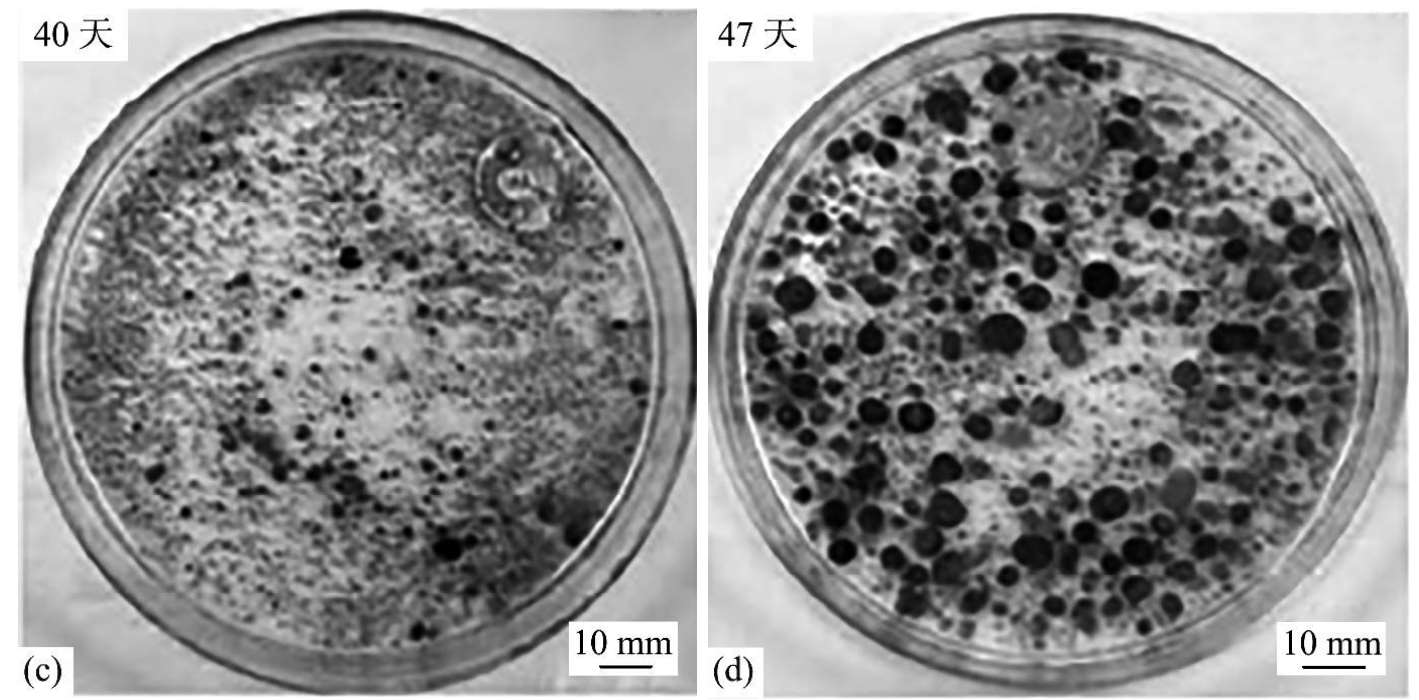
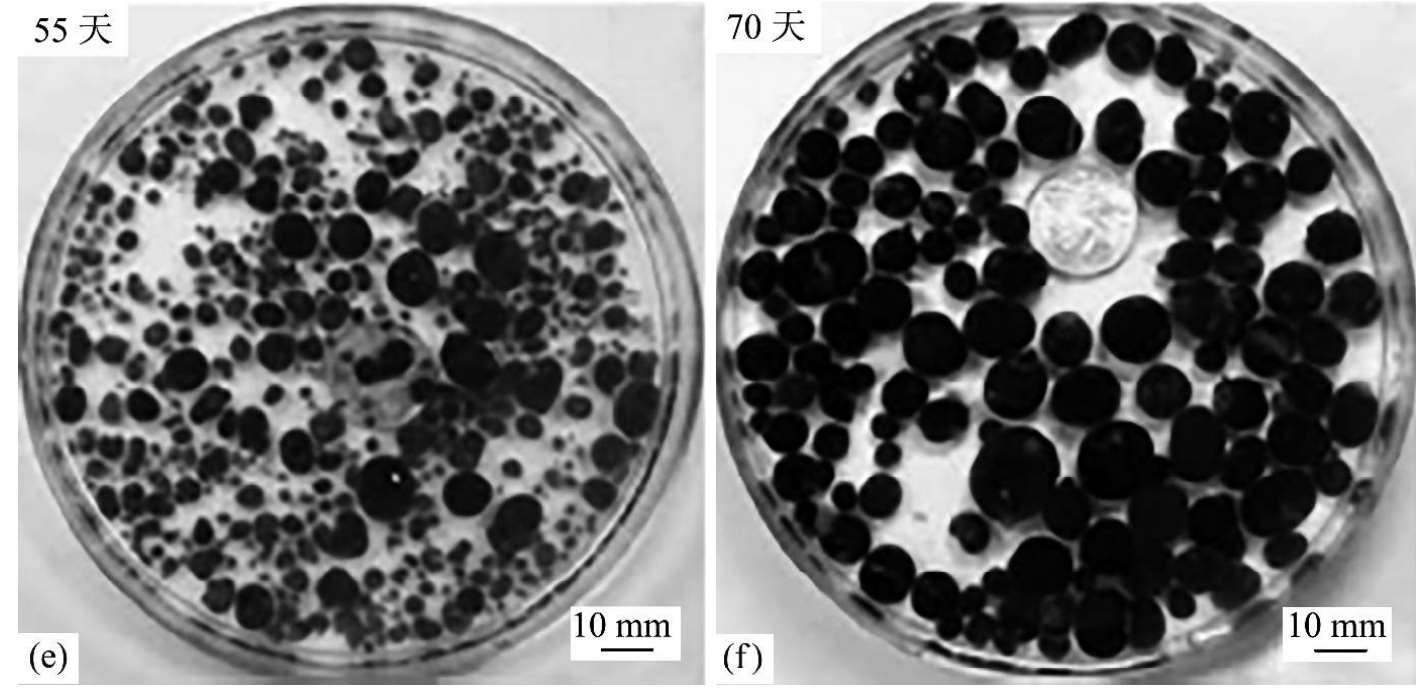

好氧颗粒污泥失稳原因主要包括丝状菌大量繁殖 [88] 、颗粒内部厌氧内核水解 [89,90] 、功能菌丧失 [91] 和EPS成分改变 [2] 。目前关于强化长期运行过程中好氧颗粒污泥稳定性的策略主要包括提供适宜的运行条件、筛选富集生长速率慢的微生物、抑制颗粒内部厌氧活性和强化颗粒内核 [2,4] 等方式。
Li等 [92] 发现在低OLR[<0.5 Kg COD/(m 3 ·d)]条件下可以培养出以真菌为主体的好氧颗粒污泥,而在OLR为2 Kg COD/(m 3 ·d)的条件下运行100天后,好氧颗粒污泥中真菌会逐渐消失,由此推断相对较高的OLR[>2 Kg COD/(m 3 ·d)]是控制真菌膨胀并提高好氧颗粒稳定性的有效手段(图1.14)。
Sdav等 [93] 研究发现较低的OLR[<2 Kg COD/(m 3 ·d)]会限制丝状菌繁殖,适当提高OLR后,细胞会迅速繁殖,但是过度提高OLR[>20 Kg COD/(m 3 ·d)]会使部分菌体的特性及功能发生紊乱,最终导致颗粒解体,由此指出培养好氧颗粒污泥时OLR的适宜取值范围是5~10Kg COD/(m 3 ·d)。Zheng等 [89] 利用蔗糖培养好氧颗粒污泥时发现,在OLR为6 Kg COD/(m 3 ·d)的条件下,好氧颗粒污泥中细菌逐渐被丝状菌代替,最终出现颗粒解体现象(图1.15)。Moy等 [48] 指出以乙酸盐培养的好氧颗粒污泥对OLR最大承受能力为9 Kg COD/(m 3 ·d)。Liu等 [84] 在强水力选择压和高OLR的运行方式下培养的好氧颗粒污泥在运行14天后失稳,适当调整OLR,使OLR从12Kg COD/(m 3 ·d)降低至6Kg COD/(m 3 ·d),好氧颗粒污泥稳定运行了6个月,由此认为,好氧颗粒污泥的形成过程和长期稳定运行需要的适宜条件不同。Kim等 [94] 考察不同强度的OLR对S/O运行模式下好氧颗粒污泥形成过程的影响,提出最适OLR为2.52 Kg COD/(m 3 ·d)。比较以上结论可见,不同运行模式下成功培养好氧颗粒污泥并维持其稳定所需最适OLR不同,培养稳定的好氧颗粒污泥需要仔细斟酌OLR的选取值。


图1.14 经过120天培养的好氧颗粒污泥照片 [92]
(a)、(c)接种污泥为以细菌为主体的大粒径好氧颗粒污泥;(b)、(d)接种污泥为以真菌为主体的大粒径好氧颗粒污泥
Liu等
[88]
发现DO较低时会引起丝状菌大量繁殖,最终导致反应器崩溃,且此现象普遍发生在OLR较高的情况下。Mosquera Corral等
[65]
同样指出DO低于饱和度的40%时会导致好氧颗粒污泥失稳,主要是因为在低DO环境下,生长速率快的微生物(如丝状菌)会迅速繁殖,使好氧颗粒污泥向易被淘洗的絮状增殖方向发展。Wan等
[95]
指出DO较低(2 mg/L)时,提供
 或者亚硝氮
或者亚硝氮
 作为电子受体可以促进好氧颗粒污泥的形成过程,且颗粒内部发生的反硝化过程也有利于好氧颗粒污泥的形成。当不存在
作为电子受体可以促进好氧颗粒污泥的形成过程,且颗粒内部发生的反硝化过程也有利于好氧颗粒污泥的形成。当不存在
 或者
或者
 时,异养菌繁殖仅出现在颗粒表面的薄层内,当污泥混合溶液中存在
时,异养菌繁殖仅出现在颗粒表面的薄层内,当污泥混合溶液中存在
 或
或
 时,异养菌则会进入颗粒内层促进异养性繁殖。DuleKgurgen等
[61]
认为好氧颗粒污泥的形成过程由DO主导,而不是由剪切力决定。
时,异养菌则会进入颗粒内层促进异养性繁殖。DuleKgurgen等
[61]
认为好氧颗粒污泥的形成过程由DO主导,而不是由剪切力决定。

图1.15 活性污泥在反应器中的演化 [89]
好氧颗粒污泥是一种特殊的生物膜。Picioreanu等 [96] 指出,以慢速增殖的生物量结合扩散运输方式,形成的生物膜比较稳定。在好氧颗粒污泥中富集繁殖速率慢的微生物可以提高颗粒密实度和稳定性 [2,97] 。比如在低DO环境下筛选类似于PSOs和GSOs等慢速生长的微生物 [12] 便可以达到以上效果。
也有研究指出,慢速生长的好氧颗粒污泥结构强度大、沉降性能好、比重高。Liu等
[98]
通过逐渐提高N/COD的方式,在好氧颗粒污泥中富集生长速率慢的硝化菌体,此后好氧颗粒污泥的生长速率和粒径增长趋势随之降低(图1.16),由此推断此类菌体与颗粒慢速增长相关。Wang等
[97]
研究发现,逐渐提高
 负荷(从50mg/L增至200mg/L)不仅可以筛选硝化菌,又能有效地抑制丝状菌的繁殖,继而实现污泥颗粒化并提高其稳定性。当
负荷(从50mg/L增至200mg/L)不仅可以筛选硝化菌,又能有效地抑制丝状菌的繁殖,继而实现污泥颗粒化并提高其稳定性。当
 投加量低于50 mg/L时,好氧颗粒污泥会发生丝状菌膨胀,颗粒运行至131天时开始破碎,而
投加量低于50 mg/L时,好氧颗粒污泥会发生丝状菌膨胀,颗粒运行至131天时开始破碎,而
 投加量高于200 mg/L时,FS的抑制作用会限制好氧颗粒污泥的形成。
投加量高于200 mg/L时,FS的抑制作用会限制好氧颗粒污泥的形成。

图1.16 不同N/COD时微生物颗粒粒径变化 [98]
此外,利用
 或者
或者
 的反硝化菌体同样可以具有较慢的繁殖速率,而且强化反硝化菌体在缺氧环境下还原
的反硝化菌体同样可以具有较慢的繁殖速率,而且强化反硝化菌体在缺氧环境下还原
 或者
或者
 可以降低曝气产生的能耗
[4]
。Sdav等
[93]
检测到颗粒外层中寄居着硝化菌和反硝化异养菌,在交替的好氧_缺氧(O/S)运行模式下此类好氧颗粒污泥可以有效地将
可以降低曝气产生的能耗
[4]
。Sdav等
[93]
检测到颗粒外层中寄居着硝化菌和反硝化异养菌,在交替的好氧_缺氧(O/S)运行模式下此类好氧颗粒污泥可以有效地将
 转化为N
2
。
转化为N
2
。
颗粒外层活性高,会消耗大部分DO,结合传质阻力,使颗粒内层呈现厌氧状态 [99,100] 。在无外源基质的环境下,长期处于饥饿状态的菌体会进行内源性呼吸,消耗EPS,易使颗粒内部出现空洞(图1.17) [101] 。抑制颗粒内部厌氧活性可以显著提高好氧颗粒污泥长期稳定性,但是目前关于抑制好氧颗粒污泥内部厌氧活性的研究成果较少。Sdav等 [102] 发现在较低温度下(-20℃),以苯酚培养的好氧颗粒污泥比以乙酸盐培养的好氧颗粒污泥更易于保存,且提供适宜浓度的苯酚可以抑制颗粒内部微生物厌氧活性,提高储存过程中好氧颗粒污泥的稳定性。另外,有研究指出排除大粒径污泥可以降低内部厌氧菌株产生的威胁 [4] 。Zhu等 [103] 在反应器底部选择性排除老化颗粒,提高颗粒的稳定性,但是其反应器仅运行60天,缺乏对好氧颗粒污泥长期运行稳定性的考察。


图1.17 饥饿14天好氧颗粒污泥的CLSM图 [101]
强化厌氧内核的研究主要是围绕对EPS展开的,这是因为EPS是组成好氧颗粒污泥骨架的主要物质,决定其运行过程的稳定性 [104,105] 。好氧颗粒污泥失稳与PS和PN的浓度变化密切相关 [101] 。Sdav等 [106] 选择性水解 α -PS、PN和油脂均不会影响颗粒污泥的三维结构,但是在选择性水解β-PS后,好氧颗粒污泥发生破碎,因此推断β-PS构建好氧颗粒污泥的骨架,α-PS、PN和油脂镶嵌在骨架中为好氧颗粒污泥结构提供支撑作用。Lin等 [107] 指出微生物分泌的藻朊酸盐类似物会与Ca 2+ 发生反应,可提高好氧颗粒污泥的稳定性。Jiang等 [68] 证实Ca 2+ 会提高好氧颗粒污泥中PS含量。Ren等 [108] 发现富含Ca 2+ 的好氧颗粒污泥具有较高的压缩强度,这可能与颗粒内形成的含钙沉淀相关。但是以上研究需要额外添加辅助材料,会增大操作复杂性和运行费用。